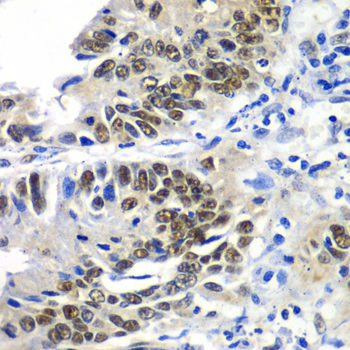
Immunohistochemistry - DACH1 Polyclonal Antibody

-
Product Name
DACH1 Polyclonal Antibody
- Documents
-
Description
Polyclonal antibody to DACH1
-
Tested applications
WB, IHC
-
Species reactivity
Human, Mouse, Rat
-
Alternative names
DACH1 antibody; DACH antibody; dachshund homolog 1 antibody
-
Isotype
Rabbit IgG
-
Preparation
Antigen: Recombinant fusion protein containing a sequence corresponding to amino acids 450-570 of human DACH1 (NP_542937.2).
-
Clonality
Polyclonal
-
Formulation
PBS with 0.02% sodium azide, 50% glycerol, pH7.3.
-
Storage instructions
Store at -20℃. Avoid freeze / thaw cycles.
-
Applications
WB 1:200 - 1:2000
IHC 1:20 - 1:200 -
Validations
Immunohistochemistry - DACH1 Polyclonal Antibody
Immunohistochemistry of paraffin-embedded human colon carcinoma using DACH1 antibody at dilution of 1:100 (40x lens).
-
Background
Transcription factor that is involved in regulation of organogenesis. Seems to be a regulator of SIX1, SIX6 and probably SIX5. Corepression of precursor cell proliferation in myoblasts by SIX1 is switched to coactivation through recruitment of EYA3 to the SIX1-DACH1 complex. Transcriptional activation seems also to involve association of CREBBP. Seems to act as a corepressor of SIX6 in regulating proliferation by directly repressing cyclin-dependent kinase inhibitors, including the p27Kip1 promoter (By similarity). Inhibits TGF-beta signaling through interaction with SMAD4 and NCOR1. Binds to chromatin DNA via its DACHbox-N domain (By similarity).
Related Products / Services
Please note: All products are "FOR RESEARCH USE ONLY AND ARE NOT INTENDED FOR DIAGNOSTIC OR THERAPEUTIC USE"
